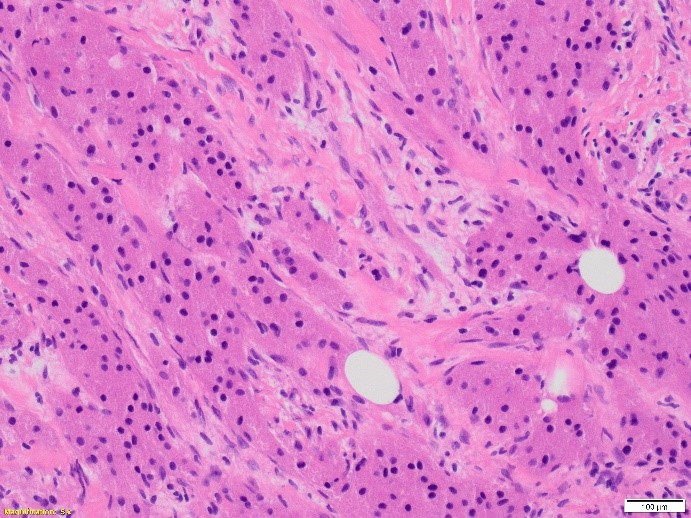
dal_zotto_case_2_2023.jpg

Case History
A 32-year-old female with a left breast suspicious mass at 12:00 o’clock underwent a needle biopsy.

What is the most likely diagnosis?
A. Granular cell tumor
B. Langerhans cell histiocytosis
C. Metastatic melanoma
D. Apocine carcinoma
E. Fat necrosis
Answer A. Granular cell tumor
Discussion:
Granular cell tumors (GCT) are most common in the tongue, skin, and subcutaneous tissue. As many as 8% of all granular cell tumors arise in the breast at a wide age range (19-77 years).
Granular cell tumors show peripheral nerve sheath (Schwannian) differentiation. Genetic profiling has revealed frequent loss-of-function mutations in the ATP6AP1 and ATP6AP2 genes located in chromosome X, explaining the higher prevalence of these tumors in women.
On microscopic exam, GCT has an infiltrative growth pattern composed of sheets, clusters, and trabeculae of large, round to polygonal cells with abundant, eosinophilic, and distinctly granular cytoplasm. Their granular cytoplasm is the results from cytoplasm accumulation of secondary lysosomes.
The diagnosis of granular cell tumor is usually straightforward. In the breast, the differential diagnosis is with carcinomas (particularly apocrine carcinomas) given the epithelioid appearance of the cells and the frequent presence of perineural and perivascular involvement in otherwise benign granular cell tumor.
By immunohistochemistry, GCT can be distinguished from carcinomas, since they are negative with keratins and show strong and diffuse S-100 protein expression. Caution should be exercise in only consider S100 as standalone stain, since some breast carcinomas can be positive with this marker. Ultimately, the cytomorphology with nuclear atypia and mitosis in carcinomas, help in the differential diagnosis.
Other lesions with abundant histiocytes in the breast, such as areas in proximity to fat necrosis and duct ectasia with histiocytic accumulation also should be considered. The features of the background parenchyma with chronic inflammation, cystic spaces, and foreign body-type giant cells can help in the distinction.
Metastatic neoplasms, such as melanoma should be considered in the differential diagnosis. Unlike melanoma, granular cell tumors are negative for HMB-45 and Melan-A. Histiocytic neoplasms, such as fibrohistiocytoma, Langerhans cell histiocytosis and Rosai-Dorfman disease can share with GCT positivity for CD68 and S100. Relationship with the overlying skin in the case of a cutaneous fibrohistiocytoma, and associated inflammatory polymorphous background in histiocytic neoplasms may help in the differential. Alveolar soft part sarcoma share with granular cell tumor epithelioid appearance and strong nuclear expression of TFE3. However, cytokeratin and S100 will be negative.
Most granular cell tumors are benign and local excision is curative. Local recurrences are rare and occur after incomplete excisions. Less than 1% of granular cell tumors are malignant. Criteria for malignancy in granular cell tumors include large tumor size (>5 cm), pleomorphism, high nuclear-to-cytoplasmic ratio, vesicular nuclei with large nucleoli, cell spindling, more than two mitoses per 10 high-power fields, and tumor necrosis.
References:
Lazar AJ, Schnitt SJ, Bui M, Reis-Filho JS, Mahar AM, Granular cell Tumor. In: WHO Classification of Tumours Editorial Board. Breast tumours. Lyon (France): International Agency for Research on Cancer; 2019. (WHO classification of tumours series, 5th ed.; vol. 2). https://publications.iarc.fr/581.
Schnitt SJ, Collins LC. 2009. Biopsy Interpretation of The Breast. Wolters Kluwer Lippincott Williams & Wilkins
Chamberlain BK et al. Alveolar soft part sarcoma and granular cell tumor: an immunohistochemical comparison study. Human Pathol. 2014; 45: 1039-1044
Case contributed by Valeria L. Dal Zotto, M.D., Assistant Professor, Anatomic Pathology, UAB Department of Pathology